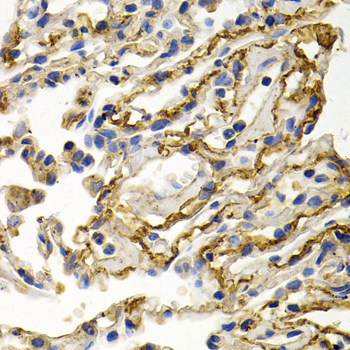
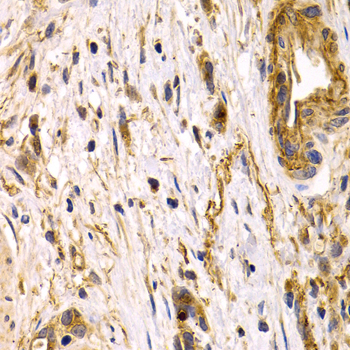

For quotations, please use our online quotation form, and you may also contact us by
service@kendallscientific.com
+1-888.733.6849 (Toll-free)
+1-617.299.7367 (Int’l))
+1-888.733.6849
Our customer service representatives are available 24 hours, Monday through Friday to assist you.| Reactivity | Human Mouse Rat |
| Tested applications | WB IHC IF |
| Recommended Dilution | WB 1:500 - 1:2000 IHC 1:50 - 1:200 IF 1:50 - 1:200 |
| Calculated MW | 53kDa |
| Observed MW | Refer to Figures |
| Immunogen | Recombinant protein of human CLU |
| Storage Buffer | Store at -20℃. Avoid freeze / thaw cycles. Buffer: PBS with 0.02% sodium azide, 50% glycerol, pH7.3. |
| Concentration | b |
| Synonym | CLI; AAG4; APOJ; CLU1; CLU2; KUB1; SGP2; APO-J; SGP-2; SP-40; TRPM2; TRPM-2; NA1/NA2 |

Western blot analysis of extracts of various cells, using CLU antibody.
Immunohistochemistry of paraffin-embedded human lung cancer using CLU antibody at dilution of 1:200 (400x lens).
Immunohistochemistry of paraffin-embedded human stomach cancer using CLU antibody at dilution of 1:200 (400x lens).

Immunofluorescence analysis of U20S cell using CLU antibody. Blue: DAPI for nuclear staining.
The protein encoded by this gene is a secreted chaperone that can under some stress conditions also be found in the cell cytosol. It has been suggested to be involved in several basic biological events such as cell death, tumor progression, and neurodegenerative disorders. Alternate splicing results in both coding and non-coding variants.
N/A